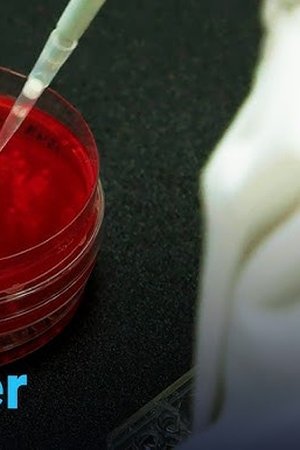
104. epizoda

DW Documentary – 9. 9. sezóna

- Originální název: DW Documentary
- Žánr: Dokumentární
- Premiéra: 4. 1. 2025
Díly
Informace o postavách seriálu
Zajímavosti k sezóně
Žádná zajímavost není k dispozici, přidej nějakou.
Trailer
Žádný trailer není k dispozici.
Hlášky ze sezóny
Chyby v sezóně
Žádná chyba v sezóně není evidovaná.
Soundtrack
V přípravě.